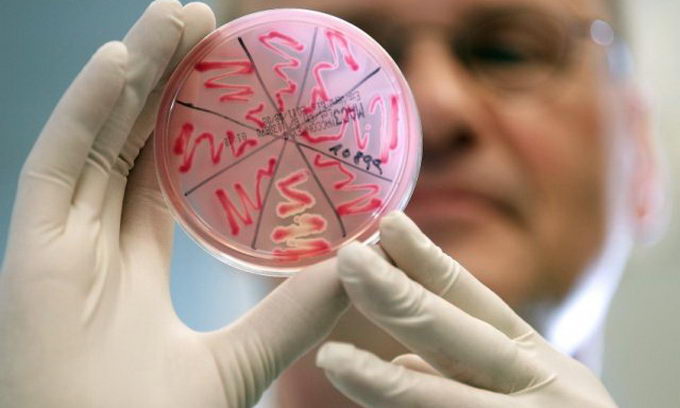

ВООЗ: Європу вразив досі невідомий тип кишкової палички
За даними Всесвітньої організації охорони здоров’я (ВООЗ), штам ентерогеморрагічної кишкової палички (EHEC, ЕГКП), що викликав епідемію в Європі, не був відомий раніше.
За даними Всесвітньої організації охорони здоров’я (ВООЗ), штам ентерогеморрагічної кишкової палички (EHEC, ЕГКП), що викликав епідемію в Європі, не був відомий раніше.
Результати лабораторних досліджень антигенів бактерії показали, що вона є штамом O104: H4, який раніше не ставав причиною захворювання людей. Попередні результати секвенування бактеріальної ДНК свідчать про те, що цей штам раніше не виявлявся при аналізах, і є мутантом, що містить гени двох різних типів кишкової палички, пише DT.UA.
За словами експерта ВООЗ з безпеки харчових продуктів Хільде Круз (Hilde Kruse), новий штам ЕГКП володіє «низкою характеристик, що підвищують вірулентність і продукцію токсинів». Згідно з епідеміологічними спостереженнями, зараження кишковою паличкою O104: H4 часто ускладнюється гемолітико-уремічним синдромом (ГУС), який загрожує гострою нирковою недостатністю, ураженням центральної нервової системи і є загрозливим для життя.
До теперішнього часу епідемія викликаної ЕГКП інфекції, що почалася на півночі Німеччини, вразила більше 1,5 тисячі осіб, 17 із яких померли. Майже у 500 осіб, які заразилися, розвинувся ГУС. Випадки захворювання, завезені з Німеччини, зареєстровано у Швеції, Данії, Голландії та Великобританії; їхня кількість продовжує збільшуватися.
Нагадаємо, 31 травня міністр охорони здоров'я в уряді Гамбурга Корнелія Прюфер-Штрокс заявила, що іспанські огірки не є джерелом гострої кишкової інфекції, від якої у Німеччині вже померли 14 людей. Раніше іспанська продукція вважалася винуватцем зараження, яке вразило 1,2 тис. німців. Тепер джерело зараження необхідно шукати заново.
В Україні інфекції поки виявлено не було. Сьогодні Прем'єр-міністр України Микола Азаров заявив, що Україна посилила контроль на кордоні за ввезенням овочів з країн Європейського Союзу.






